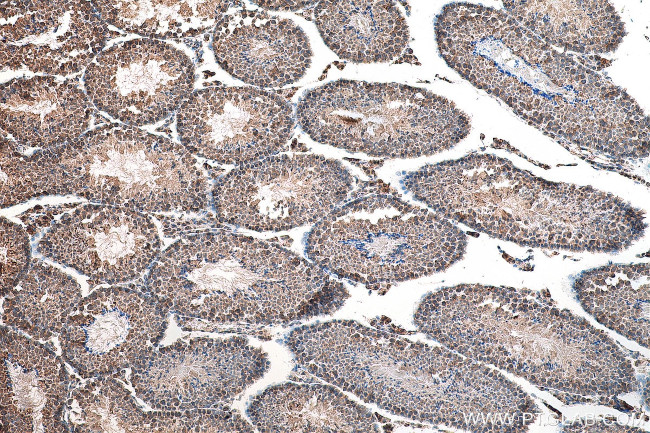
IFT81 Antibody in Immunohistochemistry (Paraffin) (IHC (P))

Search
Proteintech
IFT81 Polyclonal Antibody
{{$productOrderCtrl.translations['antibody.pdp.commerceCard.promotion.promotions']}}
{{$productOrderCtrl.translations['antibody.pdp.commerceCard.promotion.viewpromo']}}
{{$productOrderCtrl.translations['antibody.pdp.commerceCard.promotion.promocode']}}: {{promo.promoCode}} {{promo.promoTitle}} {{promo.promoDescription}}. {{$productOrderCtrl.translations['antibody.pdp.commerceCard.promotion.learnmore']}}
产品信息
10604-2-AP
种属反应
宿主/亚型
分类
类型
抗原
偶联物
形式
浓度
规格
纯化类型
保存液
内含物
保存条件
运输条件
产品详细信息
Immunogen sequence: FLQDETVAD TNKQYEELME AFKTLHKEYE QLKISGFSTA EIRKDISAME EEKDQLIKRV EHLKKRVETA QNHQWMLKIA RQLRVEKERE EYLAQQKQEQ KNQLFHAVQR LQRVQNQLKS MRQAAADAKP ESLMKRLEEE IKFNLYMVTE KFPKELENKK KELHFLQKVV SEPAMGHSDL LELESKINEI NTEINQLIEK KMMRNEPIEG KLSLYRQQAS IISRKKEAKA EELQEAKEKL ASLEREASVK RNQTREFDGT EVLKGDERQD LTLSPRLECG GVIMAYCSLK LLGSSDPPTS AS (131-431 aa encoded by BC004536)
靶标信息
Isoform CDV-1 may be involved in cardiac hypertrophy caused by carnitine deficiency. Isoform CDV-1R appears to play a role in development of the testis and spermatogenesis.
仅用于科研。不用于诊断过程。未经明确授权不得转售。
生物信息学
蛋白别名: carnitine deficiency-associated gene expressed in ventricle 1; Carnitine deficiency-associated protein expressed in ventricle 1; CDV-1; intraflagellar transport 81 homolog; Intraflagellar transport protein 81 homolog; Mus musculus CDV-1 homolog; unnamed protein product
基因别名: AW060663; CDV-1; CDV-1R; CDV1; CDV1R; DV1; IFT81; SRTD19
UniProt ID: (Human) Q8WYA0, (Mouse) O35594, (Rat) P83829
Entrez Gene ID: (Human) 28981, (Mouse) 12589, (Rat) 373066